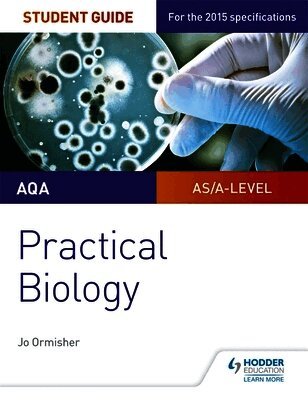

Jo Ormisher – författare
Visar alla böcker från författaren Jo Ormisher. Handla med fri frakt och snabb leverans.
5 produkter
5 produkter
Häftad, Engelska, 2017
163 kr
Skickas inom 5-8 vardagar
Exam Board: AQALevel: AS/A-levelSubject: BiologyFirst Teaching: September 2015First Exam: June 2016Ensure your students get to grips with the core practicals and develop the skills needed to succeed with an in-depth assessment-driven approach that builds and reinforces understanding; clear summaries of practical work with sample questions and answers help to improve exam technique in order to achieve higher grades.Written by an experienced teacher, this Student Guide for practical Biology:- Help students easily identify what they need to know with a concise summary of required practical work examined in the A-level specifications.- Consolidate understanding of practical work, methodology, mathematical and other skills out of the laboratory with exam tips and knowledge check questions, with answers in the back of the book.- Provide plenty of opportunities for students to improve exam technique with sample answers, examiners tips and exam-style questions. - Offer support beyond the Student books with coverage of methodologies and generic practical skills not focused on in the textbooks.
Häftad, Engelska, 2018
177 kr
Skickas inom 5-8 vardagar
Exam Board: AQA, CCEA, Edexcel, OCR, WJEC/EduqasLevel: A-levelSubject: BiologyFirst teaching: September 2015First exams: Summer 2017Master the skills you need to set yourself apart and hit the highest grades; this year-round course companion develops the higher-order thinking skills that top-achieving students possess, providing step-by-step guidance, examples and tips for getting an A grade.Written by experienced author and teacher Jo Ormisher, Aiming for an A in A-level Biology:- Helps you develop the 'A grade skills' of analysis, evaluation, creation and application- Takes you step by step through specific skills you need to master in A-level Biology, including scientific reading, quantitative and practical skills , so you can apply these skills and approach each exam question as an A/A* candidate- Clearly shows how to move up the grades with sample responses annotated to highlight the key features of A/A* answers- Helps you practise to achieve the levels expected of top-performing students, using in-class or homework activities and further reading tasks that stretch towards university-level study- Perfects exam technique through practical tips and examples of common pitfalls to avoid - Cultivates effective revision habits for success, with tips and strategies for producing and using revision resources- Supports all exam boards, outlining the Assessment Objectives for reaching the higher levels under the AQA, Edexcel, OCR, WJEC/Eduqas and CCEA specifications
Häftad, Engelska, 2020
167 kr
Skickas inom 5-8 vardagar
Practise and prepare for AQA GCSE Biology with hundreds of topic-based questions and one complete set of exam practice papers designed to strengthen knowledge and prepare students for the exams.This extensive practice book raises students' performance by providing 'shed loads of practice', following the 'SLOP' learning approach that's recommended by teachers.- Consolidate knowledge and understanding with practice questions for every topic and type of question, including multiple-choice, multi-step calculations and extended response questions.- Develop the mathematical, literacy and practical skills required for the exams; each question indicates in the margin which skills are being tested.- Confidently approach the exam having completed one set of exam-style practice papers that replicate the types, wording and structure of the questions students will face.- Identify topics and skills for revision, using the page references in the margin to refer back to the specification and accompanying Hodder Education Student Books for remediation.- Easily check answers with fully worked solutions and mark schemes provided in the book.
Häftad, Engelska, 2020
246 kr
Skickas inom 10-15 vardagar
Practise and prepare for AQA GCSE Combined Science with hundreds of topic-based questions and one complete set of exam practice papers designed to strengthen knowledge and prepare students for the exams.This extensive practice book raises students' performance by providing 'shed loads of practice', following the 'SLOP' learning approach that's recommended by teachers.- Consolidate knowledge and understanding with practice questions for every topic and type of question, including multiple-choice, multi-step calculations and extended response questions.- Develop the mathematical, literacy and practical skills required for the exams; each question indicates in the margin which skills are being tested.- Confidently approach the exam having completed one set of exam-style practice papers that replicate the types, wording and structure of the questions students will face.- Identify topics and skills for revision, using the page references in the margin to refer back to the specification and accompanying Hodder Education Student Books for remediation.- Easily check answers with fully worked solutions and mark schemes provided in the book.
Häftad, Engelska, 2020
152 kr
Skickas inom 5-8 vardagar
Support students through the AQA A-level Biology specification with this write-in workbook, providing extra guidance, practice and scaffolding to reinforce understanding and improve key skills.-Develop and consolidate understanding using the practice questions to check knowledge -Build key skills and practise the different question types with maths, practical-based and synoptic questions-Support assessment preparation using exam-style questions that get progressively more difficult-Use flexibly alongside your existing textbooks and schemes of work as homework, classwork and for intervention-Enable students to mark work independently with answers and worked solutions available onlineThis book for AQA A-level Biology Year 2 covers: Energy transfers in and between organisms; Organisms respond to changes in their internal and external environments; Genetics, populations, evolution and ecosystems; The control of gene expression.